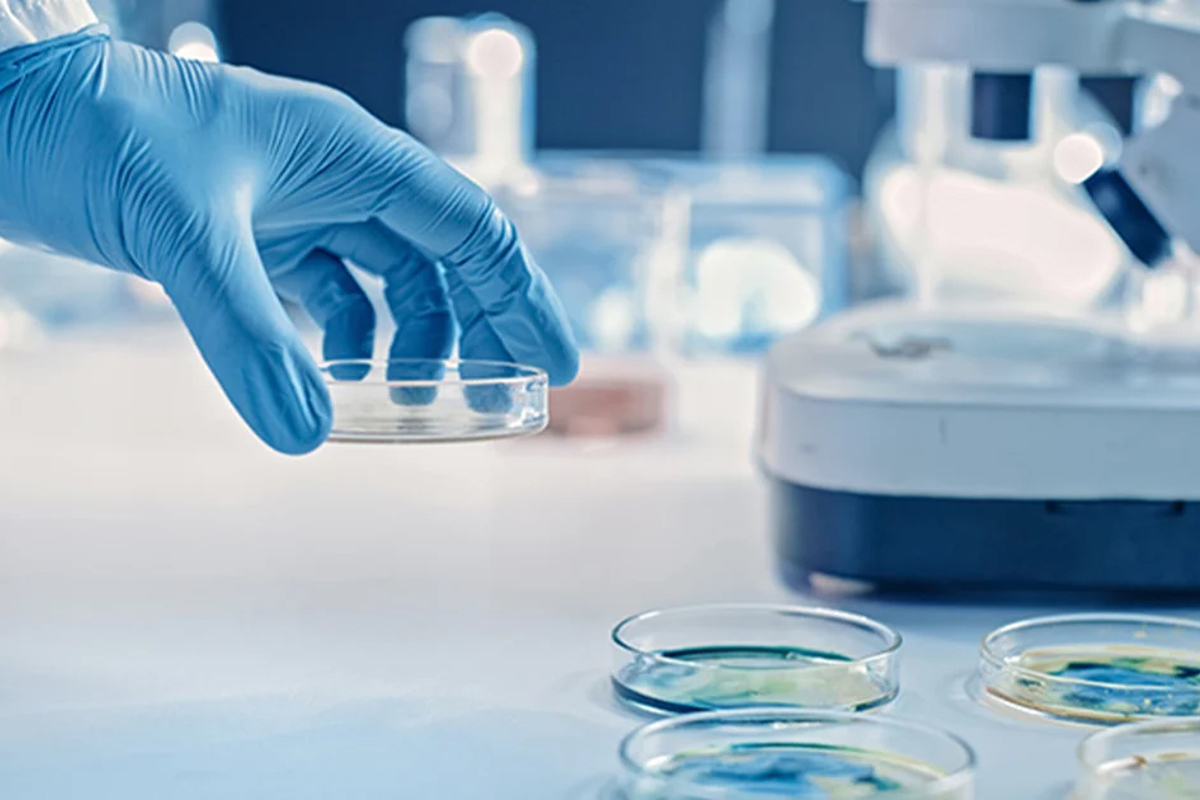

Sårdiagnostikk
Vinteren er på hell, og oppsummering av innsendt materiale til PHARMAQ Analytiq viser igjen at vi legger bak oss en utfordrende sesong mtp sår. Spesielt sår forårsaket av Moritella viscosa er fortsatt dominerende fra laks i Norge. Vår sårdiagnostikk blir hovedsakelig utført ved hjelp av bakteriologiske analyser, men også PCR benyttes for å gi prøvesvar med høyere oppløsning.
Diagnostikken denne vinteren preges i stor grad av tilsvarende funn som fra tidligere år. De fleste av de innsendte sakene domineres av funn med ulike varianter med M. viscosa, med innblanding av bakterier som Tenacibaculum sp., Aliivibrio wodanis, samt andre Aliivibrio- og Vibrio-arter. Av disse er man usikre på i hvor stor grad Aliivibrio- og Vibrio-artene kan forårsake sykdom og sår, men disse er ofte til stede i prøver fra sårfisk. Tenacibaculum-infeksjoner er oftest mest fremtredende rett etter utsett, men man finner også disse bakteriene i de samme prøvene hvor man mistenker infeksjon med M. viscosa. Det komplekse bildet gjør sårdiagnostikken utfordrende, og vi vet enda for lite om betydningen til de ulike bakterieartene i tilfeller hvor vi ser blandingskultur fra fiskegrupper med sårutfordringer.
Mengden innsendt materiale til PHARMAQ Analytiq fra sårfisk holder seg stabil sett mot foregående år. Ser vi på påvisninger av M. viscosa starter de fra sent november og øker frem til februar, hvor vi ser en topp med 58 ulike saker. Det er deretter en avtakende trend frem til slutten av april – starten av mai. Totalt har vi registrert 218 saker hvor det ble isolert M. viscosa fra november 23 – mai 24 (figur 1). En sak er definert som alt materiale som blir sendt inn fra en lokalitet med samme prøvetakingsdato.

Figur 1 - Antall saker med funn av ulike typer Moritella viscosa fordelt på måned. Merk at saker kan inneholde blandingskulturer med flere isolater per sak. Dermed vil det totale antall påvisninger av de ulike typene være høyere enn det totale antallet saker.
Ved funn av M. viscosa blir bakteriene subtypet til klassisk, klassisk ikke-viskøs eller variante isolater. Denne vinteren ser vi en overvekt av funn av klassiske ikke-viskøse isolater med totalt 169 påvisninger. Det ble også funnet variante isolater i 107 av sakene, mens kun 2 av sakene ble diagnostisert med klassiske isolater. 18 saker er ekskludert fra datasettet da det ikke var mulig å skille om isolatene var klassiske eller klassiske ikke-viskøse. Ofte ser man at klassiske ikke-viskøse isolater og variante isolater kan bli isolert fra samme fisk eller at man finner begge typene i samme anlegg på samme tid. Fra tallmaterialet ser vi at 35% av sakene hadde blandingskulturer. Enten i samme fisk eller at ulike fisk fra samme sak hadde ulike varianter av M. viscosa.
I årets vintersesong fikk vi tilsendt flest sårassosierte saker fra de sørligste produksjonsområdene (PO 1-4). Fra disse områdene har vi isolert M. viscosa fra totalt 120 saker. Vi ser at det er de klassiske ikke-viskøse isolatene som har dominert sykdomsbildet (figur 2), samtidig som det i 25% av sakene ble funnet flere ulike typer av M. viscosa. Fra produksjonsområdene i Midt-Norge (PO 5-7) mottok vi 34 saker med funn av M. viscosa. Her hadde vi omtrent like mange saker med funn av klassiske ikke-viskøse isolater og variante isolater. I Midt-Norge så vi en større andel (35%) av saker med ulike typer av M. viscosa, sammenliknet med region Sør. Fra Nord-Norge (PO 8-13) så vi en relativt lik tendens som for Midt-Norge. Av de totalt 56 sakene hvor vi påviste M. viscosa, var det henholdsvis 44 saker med klassiske ikke-viskøse isolater og 39 saker med variante isolater. Det var også 1 tilfelle med et klassisk isolat. Her var andelen av saker med funn av flere typer M. viscosa på 50%.

Figur 2 - Fordeling (%) av ulike typer Moritella viscosa per region for vinteren 23/24.
Basert på funn fra innsendt materiell til PHARMAQ Analytiq denne vinteren er det i all hovedsak funn av M. viscosa som dominerer i prøver fra sårfisk. Likevel ser vi saker med kun Tenacibaculum sp., hvor det er Tenacibaculum finnmarkense som dominerer, fra desember til april. De fleste av disse sakene kommer enten fra nyutsatt smolt eller fra utstryk fra sår etter ulike hudskader (maneter, håndtering o.l.).
PHARMAQ er verdens ledende selskap innen vaksiner og innovasjon rettet mot akvakulturnæringen og er en del av Zoetis, verdens ledende selskap innen dyrehelse. Våre innovative fiskehelseløsninger inkluderer et bredt spekter som fiskevaksiner, terapiprodukter, vaksinasjonsmaskiner inkludert servicetjenester, forskning og analyser. Selskapet leverer miljøvennlige, trygge og effektive helseprodukter til den globale akvakulturnæringen ved hjelp av målrettet forskning og engasjerte medarbeidere. Produksjon, administrasjon, forskning og utvikling ligger i Norge og med global virksomhet i kommersielle oppdrettsmarkeder har PHARMAQ rundt 375 medarbeidere. Konsernets produkter markedsføres i Europa, Nord- og Sør-Amerika samt i Asia. For mer informasjon, se selskapets hjemmeside: www.pharmaq.com. Personvernerklæring Erklæring om informasjonskapsler (cookies) Bruksvilkår
Copyright © 2020 Zoetis LLC. Alle rettigheter forbeholdt.